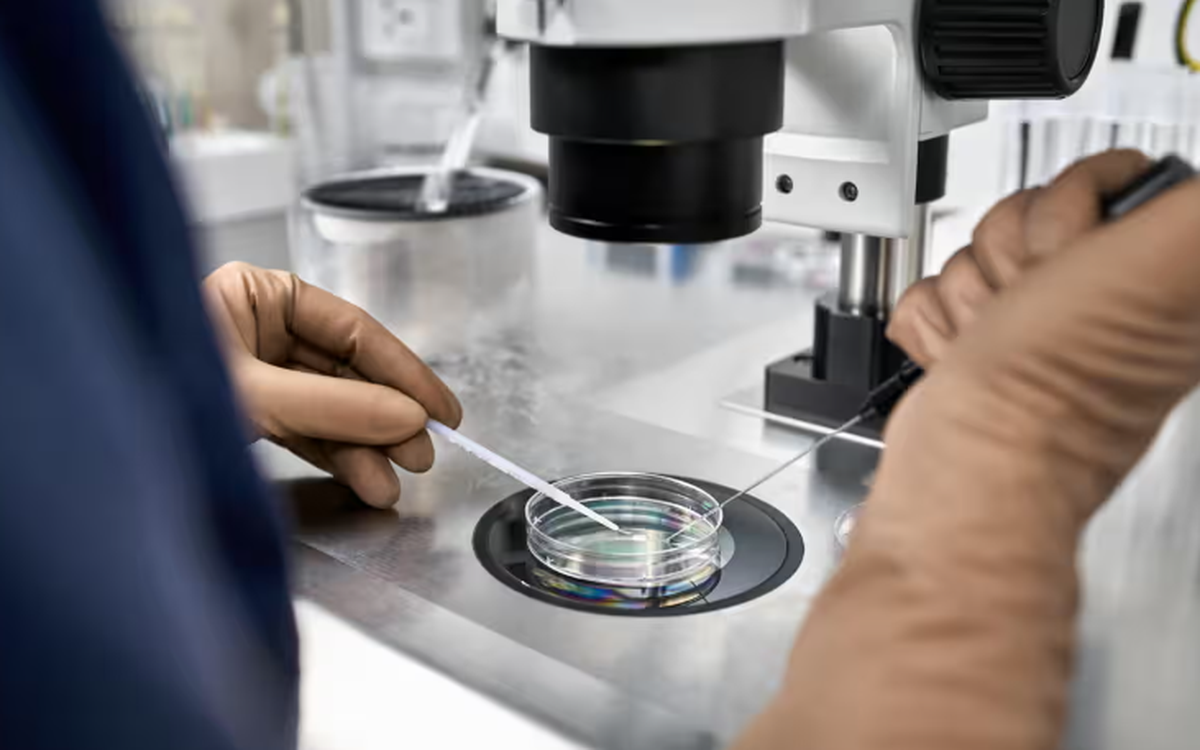
Hà Lan đối mặt nhiều vụ hôn nhân cận huyết do các phòng khám vi phạm quy định hiến tinh trùng

Nam giới trẻ tuổi bị “yếu” sớm do có 4 thói quen này

12 điều khiến sân bay Changi được yêu thích nhất thế giới

Đạo diễn trẻ Lê Diệu My đạt học bổng thạc sĩ trường ĐH Yale ở Mỹ

🔴 U18 Việt Nam vs U18 Malaysia | Thách Thức Cực Lớn

Trường THCS Năng khiếu ĐH Sư phạm công bố phương thức tuyển sinh căng thẳng

Đến Thảo cầm viên tìm hiểu về cây thuốc, kiểng lá

Đã bắt tạm giam người được 'giải cứu' trong vụ ‘bắt cóc’ trẻ em ở Cà Mau

Hà Lan đối mặt nhiều vụ hôn nhân cận huyết do các phòng khám vi phạm quy định hiến tinh trùng
Đà Nẵng xây dựng thương hiệu du lịch gắn với y tế

TP HCM họp bàn công tác phối hợp với Bình Dương, Bà Rịa – Vũng Tàu về sáp nhập
